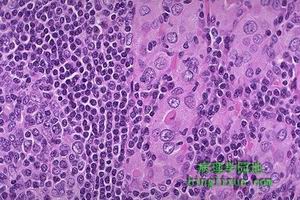
淋巴細胞性垂體炎

疾病描述
淋巴細胞性垂體炎
淋巴細胞性垂體炎1962年,Goudie和Pinkerton報導1例22歲的女性病人,同時有腺垂體炎和橋本甲狀腺炎。以後有不少學者相繼報導若干病例,表現為腺垂體炎伴腺垂體功能減退。這些病例的組織學特點是腺垂體有瀰漫性淋巴細胞浸潤,因此命名為淋巴細胞性腺垂體炎(lymphocyticadenohypophysits)。
後來的研究顯示,上述炎症性病變亦可累及神經垂體和垂體柄,稱為淋巴細胞性漏斗神經垂體炎(lymphocyticinfundibuloneurohypophysitis),臨床上主要表現為中樞性尿崩症。如病變累及整個垂體,則稱為淋巴細胞性垂體炎(lymphocytichypophysitis)。
症狀體徵
 發病過程
發病過程1.腺垂體功能低下這是淋巴細胞性垂體炎最常見和最主要的臨床表現。患者往往有乏力、嗜睡、肥胖、毛髮脫落、陽痿、閉經等症狀。其中以甲狀腺功能低下,腎上腺皮質功能低下多見。
2.溢乳不多見,可能由於:①垂體中淋巴細胞增生、浸潤、壓迫垂體柄,使下丘腦產生的催乳素抑制因子(PIF)不能到達垂體,促使PRL分泌增多。②自身抗體刺激PRL細胞,促使分泌PRI。
3.類似“垂體瘤”的症狀如頭痛、視力、視野改變。病變侵犯至頸靜脈竇,可引起動眼神經麻痹。
疾病病因
 致病細胞
致病細胞關於自身免疫的原因,目前尚不很清楚。由於絕大多數病人為妊娠或產後的婦女,因此有學者認為自身免疫可能與妊娠
 淋巴細胞性垂體炎
淋巴細胞性垂體炎目前對引起垂體自身免疫反應的自身抗原的本質尚不清楚。Crock等在淋巴細胞性垂體炎中檢測到一種抗49KDa垂體蛋白的抗體,這種49KDa抗原究竟是什麼目前也不清楚。此外,淋巴細胞性腺垂體炎的自身抗體和淋巴細胞性漏斗神經垂體炎的自身抗體也不同,前者主要針對腺垂體細胞,後者則針對分泌血管升壓素的細胞。
病理生理
在本病的發病機制尚不清楚。據文獻分析,多數作者認為是一種自身免疫疾病。由於婦女在妊娠期垂體會增生肥大,產後垂體慢慢縮小,釋放了大量垂體抗原,促使產生自身免疫反應,淋巴細胞浸潤垂體;引起垂體組織破壞。另外,Vanneste曾報導1例49歲婦女,在患病毒性腦膜炎後,發生垂體功能低下,1年後手術證實為淋巴細胞性垂體炎,據作者推測這可能是由於病毒與垂體相同的抗原,引起機體交叉反應。當然這不能排除是病毒直接感染垂體引起的。本病有許多病歷與其他免疫病同時發生,很有可能與遺傳因素有關。診斷檢查
 診斷
診斷實驗室檢查:本病的實驗室檢查顯示出自身免疫病的特點,如血沉加快,抗垂體抗體陽性。合併慢性淋巴細胞甲狀腺炎者,抗甲狀腺球蛋白抗體和微粒體及過氧化物酶抗體可陽性。有時可檢出抗腎上腺抗體、抗血小板抗體、抗平滑肌抗體、抗線粒體抗體和抗核抗體等。血CD4淋巴細胞CD8淋巴細胞比值升高。
內分泌功能檢查顯示出腺垂體功能減退及相應的靶腺功能減退的特點,但血催乳素、促甲狀腺素及生長激素水平也可升高。
其他輔助檢查:頭顱平片一般正常。不過,垂體明顯增大的病人頭顱平片也可有蝶鞍增大的表現。CT和MRI對診斷有重要的意義。本病垂體CT和MRI的表現有:垂體增大或垂體占位(可伴鞍上擴展)、垂體柄增粗、空鞍、垂體有囊性病變。垂體增大或垂體占位是最常見的影像學改變,約見於90%的病人,鞍上擴展亦相當常見(見於60%~70%的病人)。本病垂體多呈瀰漫性增大,這一點與垂體腺瘤不同,對鑑別診斷有一定的意義。垂體柄增粗則較少見,多發生於神經垂體和漏斗受累的病人。空鞍和垂體囊性病變則更為少見。久病者可有垂體萎縮但蝶鞍仍擴大。少數病人垂體CT和MRI檢查可無異常發現。
鑑別診斷
 鑑別
鑑別1.垂體腺瘤分泌性垂體腺瘤多有某種腺垂體激素過多的表現,藉此可與本病鑑別。分泌性垂體腺瘤中的PRL瘤易與本病混淆,但PRL瘤病人血PRL升高較本病更為明顯。無功能垂體腺瘤無垂體激素過多的症狀(PRL可輕至中度升高),表現為腺垂體功能減退,與本病很相似,但無功能垂體腺瘤的占位症狀(頭痛、視力減退、視野缺損等)較本病常見且顯著。此外,無功能垂體腺瘤引起的腺垂體功能減退以促性腺激素減少最先出現且最為常見,ACTH和TSH減少出現較晚且較少見;淋巴細胞性垂體炎引起的垂體功能減退則以ACTH和TSH減少較先出現,且最為常見,促性腺激素減少出現較晚,且相對少見一些。影像學檢查對垂體腺瘤和本病的鑑別有很大價值:在CT和MRI上,垂體腺瘤病人垂體為局灶性增大,本病則為瀰漫性、均質性增大;垂體腺瘤可有蝶鞍骨質的破壞,本病一般沒有。
2.細菌性垂體炎細菌性垂體炎極為罕見,為垂體的急性化膿性感染,多因細菌性腦膜炎擴散所致(極少因敗血症播散而引起)。細菌性垂體炎急性起病,病前多有化膿性腦膜炎的病史,發熱等全身症狀明顯,血象升高,藉此可與淋巴細胞性腺垂體炎鑑別。
3.垂體增生垂體增生與淋巴細胞性腺垂體炎在影像學上幾乎無法鑑別,二者的臨床表現不同。生理性垂體增生(如妊娠期的垂體增生)沒有任何臨床症狀,實驗室檢查亦無腺垂體功能減退的證據,惟血PRL水平可輕度升高;病理性垂體增生多有某種腺垂體激素增多的表現。如能獲取垂體組織作病理學檢查,則可做決定性的鑑別。
4.Sheehan綜合徵本病好發於產後,且常有腺垂體功能減退的表現,應與Sheehan綜合徵鑑別。但Sheehan綜合徵病人多有產時或產後大出血史,垂體影像學檢查可見垂體萎縮,無頭痛、視野缺損、視力受損等表現。5.壞死性漏斗垂體炎(necroticinfundibulohypophysitis)壞死性漏斗垂體炎為罕見疾病,以中樞性尿崩症為主要表現。壞死性漏斗垂體炎如累及腺垂體其表現酷似淋巴細胞性垂體炎,一般需藉助組織學檢查方能與淋巴細胞性垂體炎鑑別。垂體影像學檢查對鑑別診斷亦有意義:壞死性漏斗垂體炎多有垂體柄增粗,而淋巴細胞性垂體炎垂體柄增粗較少見。
治療方案
 藥物治療
藥物治療1.免疫抑制劑雖然沒有完整報導免疫抑制劑的治療效果,但理論上能控制疾病的發展。可用大劑量腎上腺皮質激素。
2.補充靶激素主要補充甲狀腺素、腎上腺皮質激素及性腺激素,尿崩症者套用DDAVP。
3.手術當淋巴組織浸潤嚴重,纖維增生壓迫視交視交叉影響視力、視野時,可行手術解除壓迫症狀。
食療措施
 食療
食療B.對症選用控制發熱、盜汗的食品,如豆腐渣、無花果、大麥、綠豆、苦瓜、水蛇、菱、雀麥、高粱、豆腐皮、豬心、羊肚等。
C.選用抗淋巴結腫大的食品,如芋艿、荸薺、荔枝、核桃、花紅、黃顙魚、田螺、楊度、貓肉、牡蠣等。
D.對症選用補血、止血、促進食慾、解除上腔靜脈綜合徵或皮膚瘙癢的食品,如豬肝、香蕈、芝麻、蜂乳、黃魚、花生、海參、鯢魚、薺菜、藕、葡萄、蘑菇、香菇、金針菜、木耳、鮫魚、貓肉等。
飲食禁忌:患者應該禁忌暴飲暴食和過分吃油膩之品;少用油煎、熏、烤、鹽醃製食品;禁菸、酒、辛辣刺激及霉變食物。
